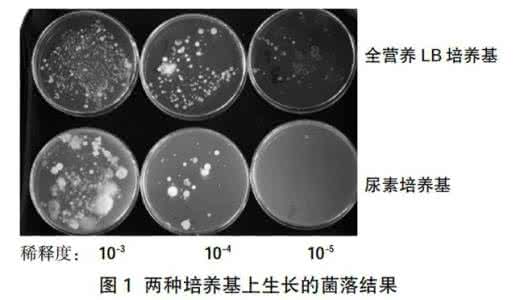
硝化细菌碳源 硝化细菌培养 培养硝化细菌的碳源、氮源和能源的依次是 A.葡萄糖、氨、葡萄糖B.葡萄糖、铵盐、太阳能C.二氧化碳

[ ]
A.葡萄糖、氨、葡萄糖
B.葡萄糖、铵盐、太阳能
C.二氧化碳、硝酸盐、氧化氨
D.二氧化碳、氨、太阳能题型:单选题难度:中档来源:0128 期中题
C
考点:
考点名称:微生物的实验室培养微生物的实验室培养:1.培养基的概念、种类及营养构成
(1)概念:人们按照微生物对营养物质的不同需求,配制出的供其生长繁殖的营养基质。
(3)营养构成:各种培养基一般都含有水、碳源、氮源、无机盐,此外还要满足微生物生长对pH、特殊营养物质以及氧气的要求。
2.无菌技术
(1)关键:防止外来杂菌的入侵。
(2)具体操作
①对实验操作的空间、操作者的衣着和手进行清洁和消毒。
②将用于微生物培养的器皿、接种用具和培养基等进行灭菌。
③为避免周围环境中微生物的污染,实验操作应在酒精灯火焰附近进行。
④实验操作时应避免已经灭菌处理的材料用具与周围的物品接触。
(3)消毒和灭菌
消毒灭菌概念使用较为温和的物理或化学方法杀死物体表面或内部的部分微生物(不包芽孢和孢子)使用强烈的理化因素杀死物体内外所用的微生物(包括芽孢和孢子)常用方法煮沸消毒法、巴氏消毒法、化学药剂消毒法、紫外线消毒法灼烧灭菌、干热灭菌、高压蒸汽灭菌适用对象操作空间、某些液体、双手等接种环、接种针、玻璃器皿、培养基等3、制备牛肉膏蛋白胨固体培养基的方法:计算、称量、溶化、灭菌、倒平板。
4、接种方法:平板划线法和稀释涂布法。
(1)平板划线操作:
①挑取他含菌样品:选用平整、圆滑的接种环,按无菌操作法挑取少量菌种。
②划A区:将平板倒置于煤气(酒精)灯旁,左手拿出皿底并尽量使平板垂直于桌面,有培养基一面向着煤气灯(这时皿盖朝上,仍留在煤气灯旁),右手拿接种环先在A区划3—4条连续的平行线(线条多少应依挑菌量的多少面定)。划完A区后应立即烧掉环上的残菌,以免因菌过多而影响后面各区的分离效果。在烧接种环时,左手持皿底并将其覆盖在皿盖上方(不要放入皿盖内),以防止杂菌的污染。
③划其他区:将烧去残菌后的接种环在平板培养基边缘冷却一下,并使B区转到上方,接种环通过A区(菌源区)将菌带到B区,随即划数条致密的平行线。再从B区作C区的划线。最后经C区作D区的划线,D区的线条应与A区平行,但划D区时切勿重新接触A、B区,以免极该两区中浓密的菌液带到D区,影响单菌落的形成。随即将皿底放入皿盖中。烧去接种环上的残菌。
④等平板凝固后,将平板倒置。
(2)稀释涂布法:是将菌液进行一系列的梯度稀释,然后将不同稀释度的菌液分别涂布到琼脂固体培养基的表面,在适宜条件下培养。在稀释度足够高的菌液里,聚集在一起的微生物将被分散成单个细胞,从而能在培养基表面形成单个的菌落。能够测定样品中活菌数的方法是:稀释涂布平板法。
纯化大肠杆菌的无菌操作和菌种保存:
1.大肠杆菌
(1)特性:革兰氏阴性、兼性厌氧的肠道杆菌。
(2)用途:是基因工程技术中被广泛采用的工具。
2.制备牛肉膏蛋白胨固体培养基
(1)计算:依据是培养基配方的比例。
(2)称量:牛肉膏比较黏稠,可同称量纸一块称取。牛肉膏和蛋白胨易吸潮,称取时动作要迅速,称后及时盖上瓶盖。
(3)溶化:牛肉膏和称量纸+水加热取出称量纸→加蛋白胨和氯化钠→加琼脂(注意:要不断用玻璃棒搅拌,防止琼脂糊底而导致烧杯破裂)→补加蒸馏水至100mL。
3.纯化大肠杆菌
(1)方法
①平板划线法:通过接种环在琼脂固体培养基表面连续划线的操作,将聚集的菌种逐步稀释分散到培养基表面。
②稀释涂布平板法:将骏业进行一系列的梯度稀释,然后将不同稀释度的菌液分别涂布到琼脂固体培养基的表面,进行培养。
(2)鉴定:将接种后的培养基和一个未接种的培养基(对照组)都放入到37℃恒温箱中,培养12h和24h后,分别观察并记录结果。
(3)菌种保存
临时保存法甘油管藏法适用对象频繁使用的菌种长期保存的菌种培养及类型固体斜面培养基液体培养基温度4℃-20℃方法菌落长成后于冰箱中保存,每3~6个月将菌种从旧的培养基转移到新鲜培养基上将培养的菌液与等体积灭菌后的甘油混合均匀后于冷冻箱内保存缺点菌种易被污染或产生变异
\
知识点拨:1、无菌技术操作原则:
(1)操作前准备:
①操作环境应清洁、宽敞、定期消毒;物品布局合理;无菌操作前半小时应停止清扫工作、减少走动、避免尘土飞扬。
②工作人员应做好个人准备,戴好帽子、口罩,修剪指甲并洗手,必要时穿无菌衣、带无菌手套。
(2)操作中保持无菌
①工作人员应面向无菌区,手臂应保持在腰部或操作台台面以上,不可跨越无菌区避免面对无菌区谈笑、咳嗽、打喷嚏。
②用无菌持物镊取用物品;无菌物品一经取出,即使未用,也不可放回无菌容器内;一套无菌物品仅供一位患者使用,避免交叉感染。 ③无菌操作中,无菌物品疑有污染或已被污染,应予更换并重新灭菌。
(3)无菌物品保管:
①无菌物品必须与非无菌物品分开放置。
②无菌物品不可暴露于空气中,应存放于无菌包或无菌容器中,无菌包外须标明物品名称、灭菌日期,并按失效期先后顺序排放。
③定期检查无菌物品的灭菌日期及保存情况。无菌包在未被污染的情况下保存期一般为7天,过期或受潮应重新灭菌。
2、划线分离操作中的有关问题:
(1)在操作的第一步以及每次划线之前都要灼烧接种环,在划线操作结束时,仍然需要灼烧接种环。
第一次灼烧每次划线之前灼烧划线结束灼烧目的避免接种环上可能存在的微生物污染培养基杀死上次划线结束后接种环上残留的菌种杀死接种环上残留的菌种,避免细菌污染或感染操作者②在灼烧接种环之后,要等其冷却后再进行划线,以免接种环温度太高,杀死菌种。
③在进行第二次以及其后的划线操作时'要从上一次划线的末端开始划线。每次划线后,线条末端细菌的数目比线条起始处要少,每次从上一次划线的末端开始,能使细菌的数目随着划线次数的增加而逐步减少,最终能得到由单个细菌繁殖而来的菌落。
(2)进行恒温培养时,要将培养皿倒置的原因如果正放培养皿,则皿盖上形成的水滴会落入培 养基表面并且扩散开。如果培养皿中已形成菌落,则茵落中的细菌会随水扩散,菌落间相互影响,很难再分成单菌落,达不到分离的目的。因此恒温培养时,培养皿必须倒置。
(3)培养后判断是否有杂菌污染的方法
①从菌落的形态看,是否湿润、透明、黏稠,呈何种颜色等等,是区别细菌、酵母菌、放线菌和霉菌的关键指标。
②用显微镜镜检观察其形态、大小,看是否有菌丝、孢子、芽孢等,这也是区别细菌、酵母菌、放线菌和霉菌的关键指标。
知识拓展:
1、对异养微生物来说,含C、N的化合物既是碳源,也是氮源,即有些化合物作为营养要素成分时并不是起单一方面的作用。
2、并不是所有微生物都需添加特殊营养物质,有些微生物需添加,原因是它们自身缺乏合成这些物质所需要的酶或合成能力有限。
3、含抗生素的牛奶不能发酵为酸奶的原因:牛奶发酵成酸奶是利用乳酸菌来完成的,乳酸菌属于细菌,
4、化学药剂的消毒方法,其作用原理是使细菌体内蛋白质变性,但是化学物质很难透过孢子或芽孢的坚硬外层进入细胞内,因此化学方法难以消灭孢子和芽孢。
5、体积分数为70%的乙醇杀菌效果最强,浓度过低,杀菌力弱,浓度过高,使菌体表面蛋白质凝固形,成一层保护膜,乙醇分子不能渗入其内,因此杀菌效果受影响。
6、倒平板的方法:右手持盛培养基的试管或三角瓶置火焰旁边,用左手将试管塞或瓶塞轻轻地拨出,试管或瓶口保持对着火焰;然后用右手手掌边缘或小指与无名指夹住管(瓶)塞(也可将试管塞或瓶塞放在左手边缘或小指与无名指之间夹住。如果试管内或三角瓶内的培养基一次用完,管塞或瓶塞则不必夹在手中)。左手拿培养皿并将皿盖在火焰附近打开一缝,迅速例入培养基约15mL,加盖后轻轻摇动培养皿,使培养基均匀分布在培养皿底部,然后平置于桌面上,待凝后即为平板。
7、在斜面培养基上接种时,其正确的操作顺序:
①用左手大拇指、食指和无名指夹住菌种试管和待接种的斜面试管,管口并齐,使斜面向上成水平状态
②右手拧松棉塞,但不取下
③右手拿接种环,在火焰上灼烧灭菌
④在火焰边用右手无名指和小指夹两个棉塞,将它们取下,同时左腕转动,灼烧管口一周
⑤将接种环伸入管内,让环先接触培养基上未长菌的部位,使环冷却,然后轻轻挑取少量菌体
⑥在火焰旁边迅速将沾有菌体的接种环伸到培养基的底部,由里向外轻轻画蛇形细线
⑦抽出接种环,再用火焰灼烧管口,并在火焰上方将棉塞塞上
8、自养型微生物与异养型微生物的培养基的主要差别在于碳源。
9、平菇培养的操作程序:配制棉籽壳培养基,高压蒸汽灭菌,接种,培养。
10、菌种的保存:对于频繁使用的菌种,可以采用临时保藏的方法;临时保藏的菌种一般是接种到试管的固体斜面培养基上;临时保藏的菌种容易被污染或产生变异;在临时保藏过程中,每3~6个月都要重新将菌种从旧的培养基上转移到新鲜的培养基上;
爱华网


